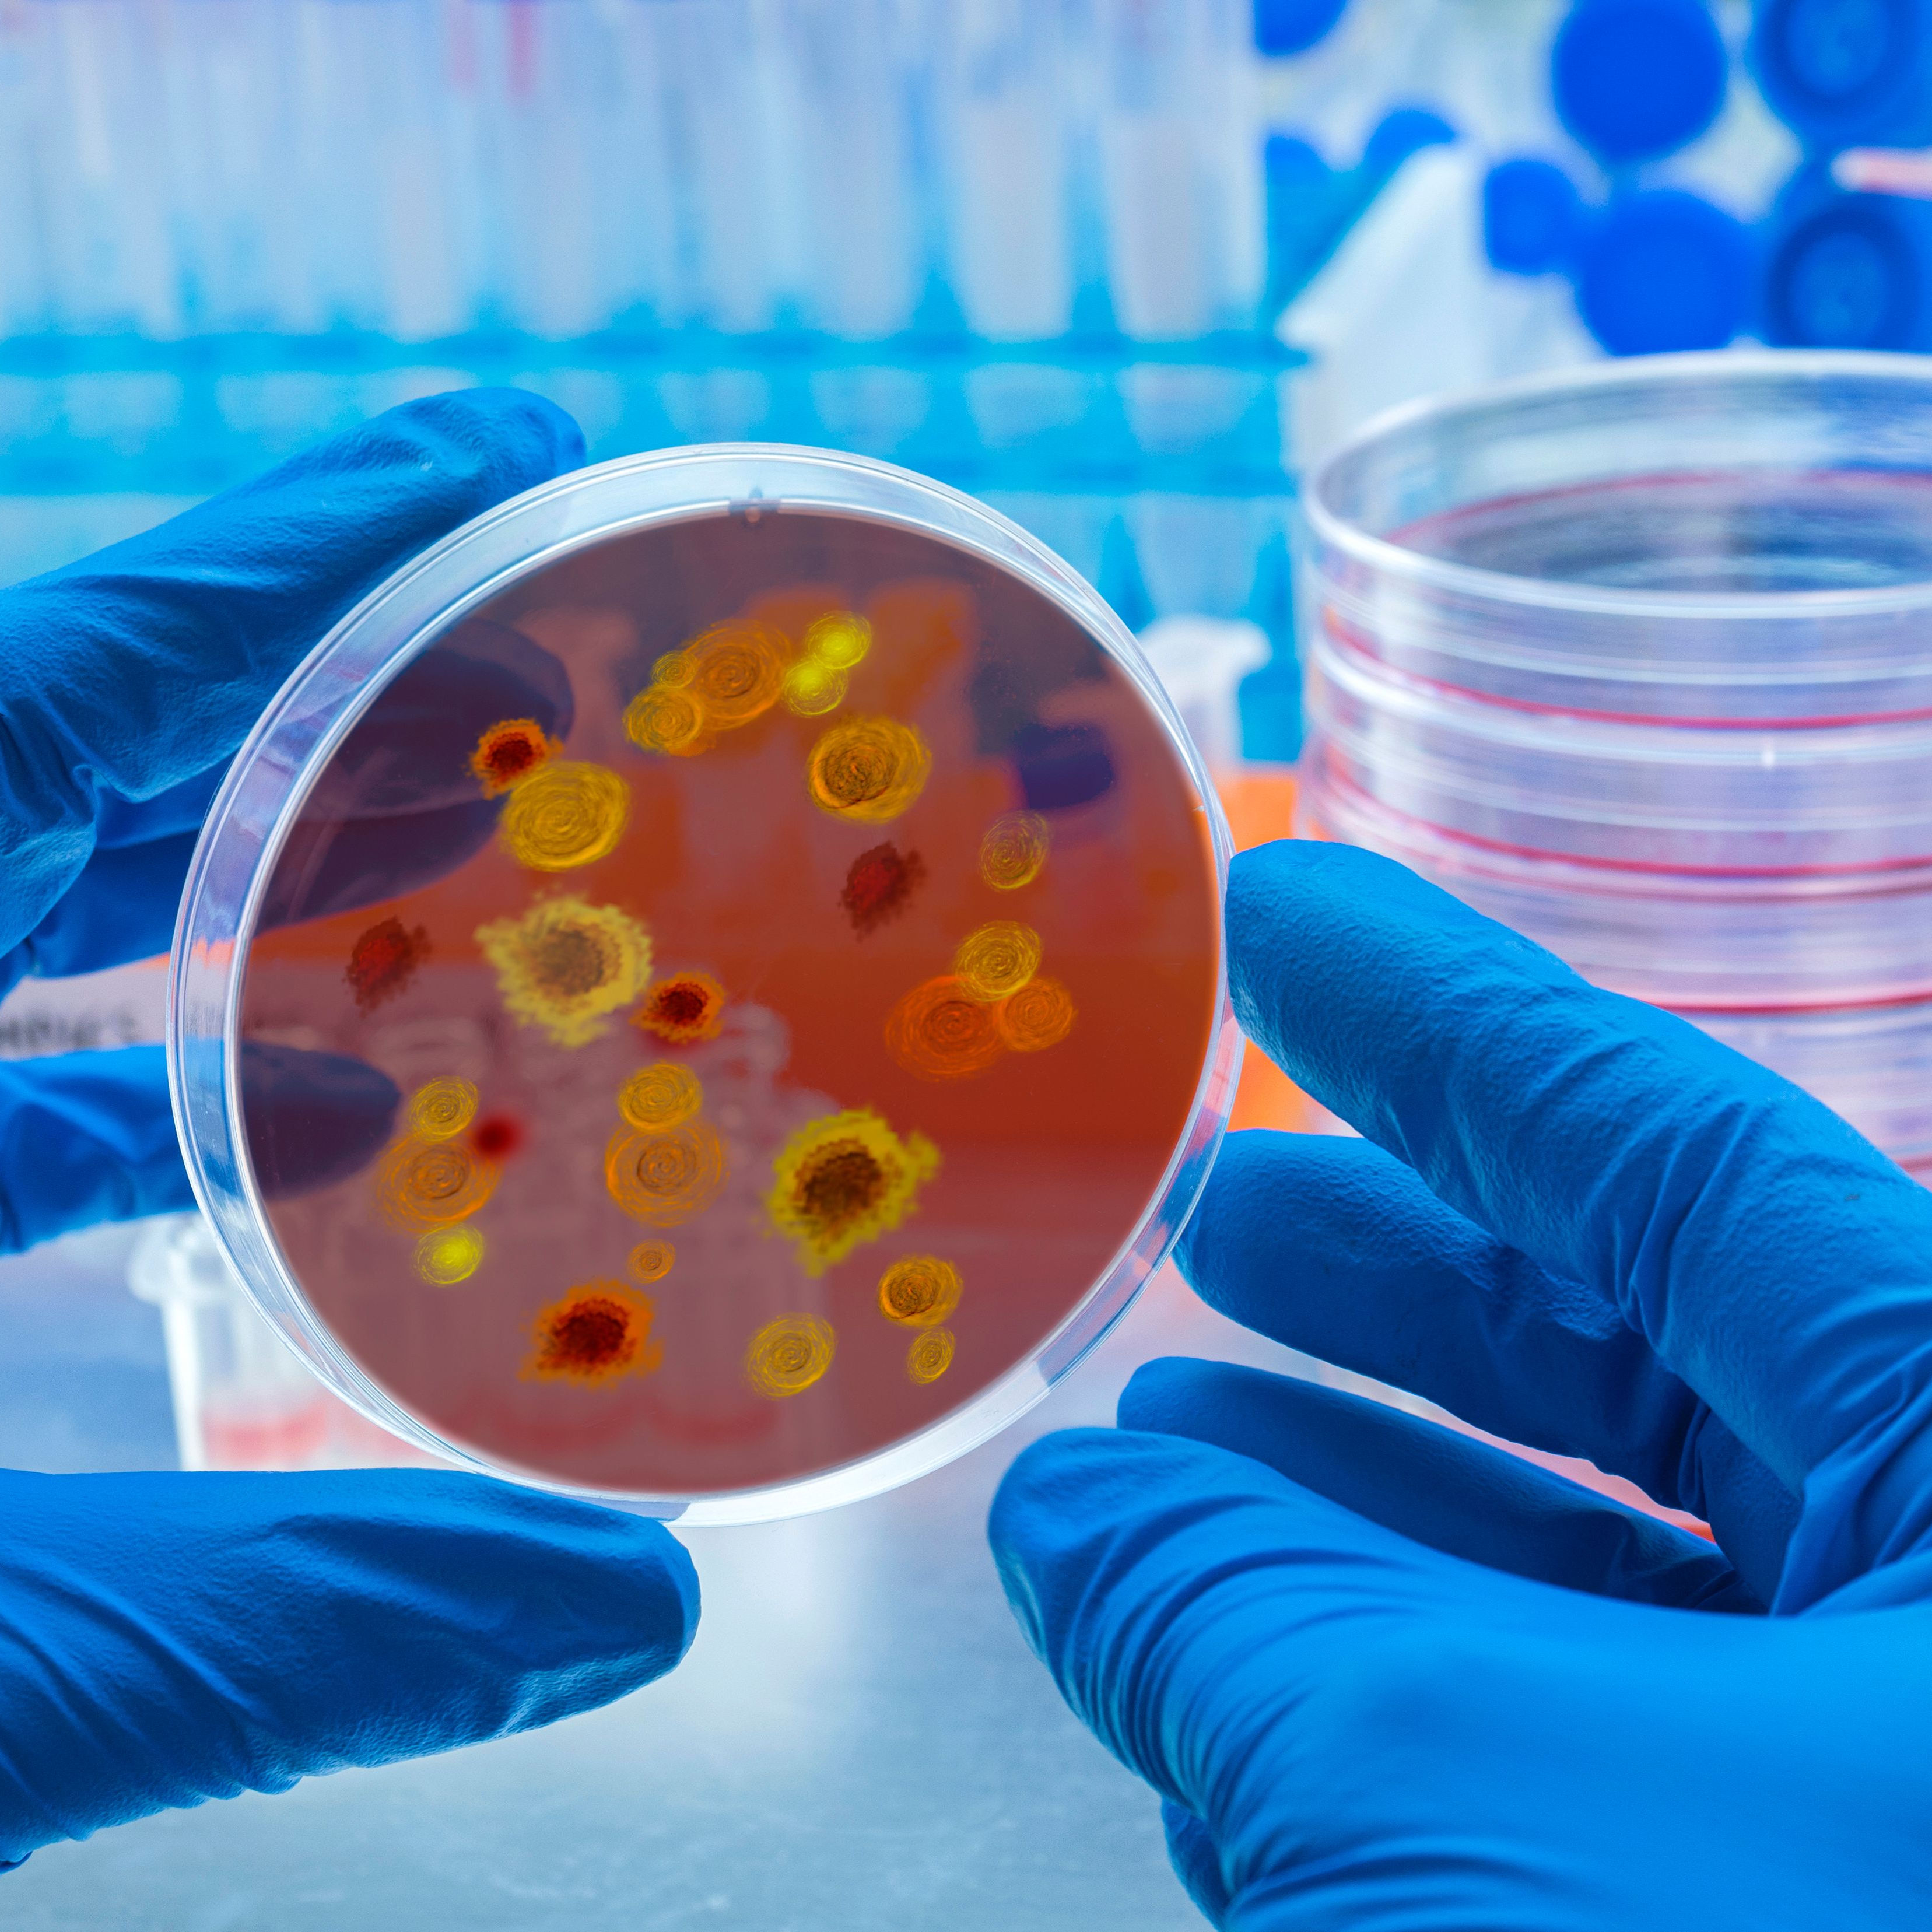

O que é o Flavivírus?
Os flavivírus pertencem à chamada Togaviridae e incluem muitas espécies diferentes que podem levar a doenças diferentes. Estas incluem a encefalite transmitida por carraças, a encefalite japonesa, a encefalite de ST Louis, a encefalite de Murray-Valley, bem como o dengue e a febre amarela. O flavivírus em si não é um único agente patogénico, mas o termo descreve o género de vírus responsável por diferentes doenças nos seres humanos.
Como é comum em muitos vírus, o material genético dos agentes patogénicos está localizado num envelope exterior que não tem organelos. Os vírus não têm o seu próprio metabolismo, pelo que dependem de um hospedeiro em cujos processos biológicos podem intervir. No caso dos flavivírus, entre outros, as células humanas também servem como um hospedeiro adequado. O vírus é então transmitido por mosquitos, carraças ou insectos semelhantes.
Quais são as características dos flavivírus?
Em média, os flavivírus têm cerca de 50 nm de tamanho e um envelope esférico de aspecto diferente, dependendo da espécie . Por exemplo, o vírus da febre amarela, também um flavivírus, tem um diâmetro de apenas cerca de 22-38 nm e é transmitido de uma pessoa para outra com a ajuda de mosquitos e carraças. Os flavivírus entram nas carraças ou mosquitos enquanto estes sugam o sangue. Se estes mordem ou picam outra pessoa, os flavivírus também a podem infectar. Isto acontece quando o vírus introduz o seu material genético na célula humana, que, por sua vez, serve de hospedeiro.
Os vírus não diferem apenas com base na sua ocorrência, mas também com base na sua transmissão. A encefalite transmitida por carraças é causada por flavivírus que entram no ser humano através de carraças em . A encefalite de St. Louise, por outro lado, é transmitida por mosquitos.
Qual é o grau de disseminação do flavivírus e onde é que ele ocorre predominantemente?
Em (Sul) da Ásia Oriental, prevalece principalmente a encefalite japonesa, que é transmitida aos seres humanos por mosquitos Culex a partir de aves e porcos . A maioria das crianças destes países contrai encefalite, que provoca sintomas como dores musculares e nos membros, febre alta e arrepios. Os mosquitos são também os principais responsáveis pela encefalite de Murray Valley. Esta forma bastante rara de encefalite é mais comum na Austrália , especialmente no norte do país. O vírus da dengue, que provoca a febre da dengue, também é transmitido por mosquitos . Acima de tudo, este flavivírus está muito disseminado no Sudeste Asiático.
Que doenças e queixas são provocadas pelo Flavivírus?
Como já foi referido em , os flavivírus são a causa de muitas doenças diferentes. No caso da encefalite, o cérebro é afectado por uma inflamação , que pode tornar-se perceptível através de vários sintomas. Os sintomas típicos são:
- Febre,
- Cãibras,
- Perturbações da consciência,
- alterações mentais.
Além disso
, podem ocorrer as chamadas síndromes focais neurológicas, nas quais
sistemas funcionais são afectados. O tipo de perturbação
depende da parte do cérebro que é afectada. Também é possível uma extensão da
encefalite às meninges e à medula espinal.
A inflamação das raízes dos nervos espinais é menos frequente. Em
alguns casos, as inflamações provocam danos irreversíveis
ou a morte do doente.
A febre amarela também é causada pela infecção por flavivírus. O quadro clínico típico é a combinação de icterícia e episódios de febre. Regra geral, a febre ocorre em episódios. Além disso, podem ocorrer os seguintes sintomas :
- Distúrbios circulatórios,
- Perturbações do fígado,
- Perturbações renais,
- Hemorragias.
A
febre do dengue, que também é provocada por flavivírus, é
tal como a febre amarela, uma doença tropical e subtropical. Para além da
febre, ocorrem normalmente os seguintes sintomas:
- Dores musculares,
- Dores musculares, dores nas articulações,
- Dores de cabeça,
- Inchaço dos gânglios linfáticos
- Erupção cutânea.
Como é que o flavivírus é diagnosticado?
Com base em uma história clínica detalhada, o médico pode já encontrar os primeiros indícios de uma infecção com o flavivírus. O doente pode ter estado numa zona de alto risco nos últimos dias. No entanto, não é possível fazer um diagnóstico definitivo com base em sintomas inespecíficos e numa história clínica. Para isso, tem de ser recolhida uma amostra de sangue.
Ao contrário de muitos outros vírus, uma infecção com o flavivírus é confirmada pela detecção de anticorpos IgM específicos no soro e anticorpos IgM no líquido cefalorraquidiano. A detecção de anticorpos IgM no LCR tem uma maior especificidade e uma maior sensibilidade para os flavivírus.
Como é que o flavivírus é tratado?
Até à data, não existe uma terapia causal contra os flavivírus. Por isso, as doenças são tratadas de forma puramente sintomática. É essencial beberes líquidos suficientes para que a febre alta não leve a uma desidratação. O repouso e a recuperação também são importantes. Para aliviar a dor e reduzir a febre, recomenda-se que tomes ibuprofeno ou paracetamol. Se tiveres febre, compressas frias na barriga da perna também podem ajudar a baixar a temperatura. Em caso de náuseas e vómitos , só deves comer alimentos leves.
Se o estado geral do doente se deteriorar, podem ser necessários cuidados médicos intensivos no hospital.
Como podes prevenir o flavivírus?
As medidas mais seguras e eficazes para prevenir o flavivírus são as seguintes:
- Usa calças compridas e roupa de manga comprida.
- Usa redes mosquiteiras,
- usa repelente de insectos suficiente,
- Evita ou elimina os pontos de água.
Há alguma obrigação de notificar o flavivírus?
De acordo com a Infektionsschutzgesetz, as suspeitas de doença, doença e também de morte por febre hemorrágica relacionada com o vírus, bem como as provas directas ou indirectas de flavivírus devem ser comunicadas pelo nome ao departamento de saúde pública . Estas notificações devem ser apresentadas o mais tardar 24 horas após a detecção.